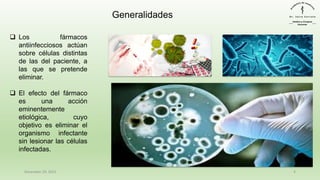
December 29, 2023 4
❑ Los fármacos
antiinfecciosos actúan
sobre células distintas
de las del paciente, a
las que se pretende
eliminar.
❑ El efecto del fármaco
es una acción
eminentemente
etiológica, cuyo
objetivo es eliminar el
organismo infectante
sin lesionar las células
infectadas.
Generalidades

El documento proporciona información general sobre los antibióticos, incluyendo su clasificación, mecanismos de acción, efectos y usos terapéuticos. Explica que los antibióticos actúan mediante la toxicidad selectiva contra microorganismos sin dañar al huésped, e inhiben la síntesis de la pared celular bacteriana o interfieren con el metabolismo de los ácidos nucleicos. También cubre aspectos como la resistencia bacteriana, factores para seleccionar un antibiótico y el uso de monoterapia frente a terap